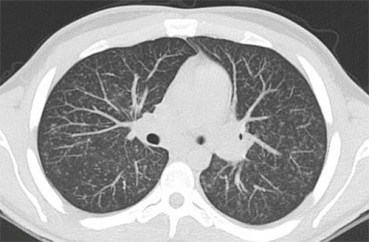
SIGNO3

Artículo publicado en el número 1 de la revista digital IMÁGENES, de la Federación Argentina de Asociaciones de Radiología, Diagnóstico por Imágenes y terapia Radiante (FAARDIT).
por Eugenio L. Navarro y Francisco Sendra
Resumen
Los libros de radiología describen numerosos signos, pero sólo se encuentran en la literatura escasas definiciones de signo radiológico, no siempre precisas. Los autores las analizan y presentan una definición propia que diferencia al signo radiológico del patrón y del hallazgo.
Se debate sobre el número de signos, impreciso y cambiante, y se enfatiza en la importancia del aprendizaje de la semiología para el reconocimiento de imágenes y el abordaje diagnóstico de determinadas patologías.
La inmensa mayoría de libros de Radiología describen numerosos hallazgos posibles en cada patología; a algunos de esos hallazgos les llaman signos, y algunos de éstos tienen un nombre, como signo de la vela marina, signo de la silueta o signo de Rigler. Pero rara vez algún autor se detiene a definir qué es signo radiológico y qué diferencia hay entre signo y hallazgo o entre signo y patrón.
El diccionario de la Real Academia de la Lengua (1) describe signo como indicio, señal de algo, lo que apenas es una aproximación lejana a la definición que pretendemos encontrar en este artículo. En medicina, signos y síntomas son alteraciones de la normalidad, relativas a una potencial situación patológica. La diferencia entre ambos radica en que los síntomas son sensaciones subjetivas referidas por el paciente y los signos son observaciones objetivadas por el médico. De esta forma, una acepción general de signo radiológico, desde una perspectiva médica, podría ser cualquier observación anormal objetivada en un estudio radiológico, por ejemplo la elevación del diafragma o la hipodensidad lineal que cruza un hueso. Pero entendemos que el signo radiológico es algo más elaborado que una simple observación objetivable, y eso es lo que pretendemos desarrollar en estas líneas.
J. Collins, en CT signs and patterns of lung disease (2), diferencia signo de patrón, referido al TAC de tórax: “signo se refiere al hallazgo radiológico que sugiere un proceso patológico específico… …patrón se refiere a un hallazgo no específico o a una colección de hallazgos que sugieren uno o más procesos patológicos específicos”.
Es cierto que algunos signos son específicos; sin embargo, no es raro encontrar signos que no señalan específicamente un proceso patológico. Más bien al contrario, pocos son los signos específicos o patognomónicos de afecciones concretas.
Eisenberg, en el prólogo de su Atlas de signos radiológicos (3), presenta una definición interesante: “Los signos son las especias de la medicina. Algunos son básicos y se usan tanto por el neófito como por el experto, mientras que otros son tan sutiles y extraños que únicamente pueden saborearse por los “gourmets” del diagnóstico. Los signos sirven como frases cortas, unas pocas palabras que se convierten en un cuadro completo y, a menudo, en un diagnóstico diferencial específico o limitado. Constituyen casi un lenguaje secreto que identifica a su usuario como un miembro reconocido de una especialidad médica”.
En esta descripción, Eisenberg aporta tres ideas interesantes: la primera, que el signo constituye un lenguaje secreto que hay que conocer para poder interpretar; la segunda, que hay diferentes niveles de dificultad en la interpretación de ese código cifrado –signos básicos y signos sutiles-, y la tercera, que el signo puede representar a un proceso patológico específico o a un diagnóstico diferencial limitado.
La Radiological Society of North America (RSNA) puso en marcha un proyecto denominado RadLex destinado a desarrollar un glosario de términos radiológicos. Este glosario, que incluye más de 30.000 entradas referentes a todos los aspectos relevantes del quehacer radiológico (tipos de exámenes, técnica, descripción de imágenes, anatomía y patología), no recoge la definición de signo radiológico. Curtis P. Langlotz, presidente del RSNA RadLex Steering Committee, respondió a un correo electrónico en el que se le preguntaba acerca de esta definición, que el Comité dedicó mucho tiempo a debatir el concepto de signo y sus equivalentes, pero por tratarse de un concepto “demasiado vago”, no fue incluido (4).
A falta, pues, de una definición precisa, en la tesis doctoral Álbum de signos radiológicos. Aplicación multimedia con fines docentes sobre semiología radiológica (5) se propone una definición de signo radiológico: imagen de un estudio radiológico que, debidamente interpretada por un profesional experto, permite diagnosticar un proceso patológico específico, elaborar un listado reducido de diagnóstico diferencial, determinar una localización específica, o bien establecer una referencia de normalidad.
Las novedades de esta definición son dos: la primera es la de conjugar la imagen radiológica con la interpretación de ésta. Así, el signo es para el radiólogo como la pista para el detective: por un lado, el hallazgo carece de valor para quien no sabe reconocerlo como tal; por otro, muchos signos radiológicos sólo se encuentran si se saben buscar. La segunda es la de que el signo no sólo permite reconocer patologías, sino también localizaciones y estructuras normales. De hecho, el signo tal vez más conocido, el signo de la silueta, es un signo localizador, y pueden citarse otros ejemplos.
Signo, hallazgo y patrón
Abundando en la indefinición sobre qué es signo radiológico baste comentar que, con alguna frecuencia, la misma imagen es descrita como signo y como patrón. Así, en el artículo citado de J. Collins se habla de patrón de “árbol en flor” (tree-in-bud pattern), al igual que otros autores (Aquino y cols) (6); la misma imagen recibe indistintamente el nombre de signo (tree-in-bud sign) y el de patrón en un trabajo de Eisenhuber (7).
El diccionario (1) puede ayudarnos a la distinción de estos conceptos, ya que, si signo es indicio o señal, hallazgo significa cosa hallada, es decir, hallazgo puede ser cualquier imagen radiológica descubierta en un estudio, sin que se tenga en cuenta su significado como imagen normal, variante de la normalidad o patológica específica o inespecífica. De esta forma, todos los signos, al ser reconocidos por el radiólogo o persona que interpreta el estudio, son hallazgos, pero pocos hallazgos son signos.
No es infrecuente el uso del término hallazgo para describir la imagen radiológica encontrada de forma casual, en un estudio, con implicaciones en el diagnóstico y tratamiento del paciente. Así un cáncer de pulmón puede ser un hallazgo en una radiografía de tórax realizada en el estudio preoperatorio de cataratas, por ejemplo.
Compartimos con J. Collins (2) la definición de patrón radiológico como conjunto de hallazgos carentes de especificidad, y no debe confundirse, por tanto, con signo. Un ejemplo de este término se encuentra en su uso para describir la lesión alveolar. En efecto, el patrón consolidativo o alveolar se define (Pedrosa) (8) por la presencia de un conjunto de hallazgos en la radiografía de tórax:
- Aumento de densidad con aspecto algodonoso en los bordes
- Tendencia a la coalescencia
- Distribución lobar o segmentaria (patrón alveolar localizado)
- Distribución en “alas de mariposa” (patrón difuso)
- Broncograma aéreo (a veces alveolograma)
- Nódulos peribronquiales
- Aparición y desaparición rápidas
La inespecificidad es notoria: más de un centenar de entidades nosológicas pueden causar este patrón.
En “The many ways of saying “pattern” in French medical text” (Band) (9), la autora –lingüista médica- enumera los usos de este término en diferentes especialidades médicas. En Radiología se utiliza como sinónimo de aspecto, estructura, ecoestructura, textura, configuración, morfología, signo, imagen y expresión, entre otros.
Las figuras 1, 2 y 3 ilustran ejemplos de signo, hallazgo y patrón.
Figura 1. Signo de la C2 ancha. Consiste en un aumento de la distancia entre el margen anterior y el posterior de C2 en relación con C3. Corresponde a una fractura oblicua del cuerpo vertebral con desplazamiento de un fragmento sobre el otro, dando la apariencia de un agrandamiento del diámetro anteroposterior. Según la oblicuidad de la línea de fractura, ésta puede no verse en la radiografía.
Figura 2. Ejemplo de hallazgo. Se ven dos nódulos pulmonares encontrados de forma casual en un estudio preoperatorio. Correspondían a metástasis de un cáncer de colon no conocido.
Figura 3. Ejemplo de patrón. La presencia de múltiples nódulos intersticiales, de pequeño tamaño y distribución difusa define al patrón miliar, que puede estar causado por enfermedades granulomatosas infecciosas, y no infecciosas, sarcoidosis, neumoconiosis, metástasis, etc. En este caso se trataba de un paciente VIH + con tuberculosis miliar.
El número de signos
Si resulta difícil encontrar una definición precisa y definitiva de signo, no lo es menos establecer su número. A medida que se han desarrollado nuevos métodos de imagen y se han ido conociendo nuevas patologías, se ha incrementado notablemente el número de signos. Tal es así, que ninguna recopilación hecha hasta ahora ha podido ser completa. Radiology publicó, entre 1999 y 2008 un total de 118 signos en su sección Signs in imaging. La web Radswiki (10) recoge 211. Eisenberg presenta más de 350 signos en Atlas de signos radiológicos. El Diccionario de signos radiológicos (11) contiene 816 registros. Finalmente, el Dr. Rosas Lavado parece decidido a pulverizar todos los registros. Su obra Signos en radiología músculo-esquelética (12) muestra 104 signos sólo de este área, y prepara otra publicación sobre signos torácicos con 211 registros (13).
De la nómina de la semiología hay que dar de baja a multitud de signos. La llegada de nuevas técnicas ha relegado al olvido algunas exploraciones (la neumoencefalografía, la ventriculografía, la colecistografía oral,…) y muchas indicaciones de estudios (arteriografía en el estudio de tumores cerebrales o renales,…), así como toda la semiología de estas exploraciones. Otros signos abandonados son aquellos descritos con excesivo entusiasmo por ser muy específicos o patognomónicos de determinada patología, pero que estudios posteriores restaron especificidad y, en algunos casos, hicieron tan amplia la lista de diagnósticos posibles, que el signo quedó en una anécdota para la historia, como ocurre con el signo del halo en los nódulos mamarios (14).
Clasificación de los signos
No hay ninguna clasificación de los signos radiológicos, salvo la de su adscripción al área anatómica en el que se encuentra la patología que representa el signo. Así, autores como el citado Eisenberg (3), clasifica los signos de su Atlas según pertenezcan al tórax, al aparato digestivo o al sistema esquelético, entre otros.
Otra forma de organizarlos es atendiendo a la técnica de imagen en la que se presentan: así, hay una semiología en los estudios de radiología convencional, una semiología ecográfica y signos en los estudios de TAC y Resonancia Magnética. Con frecuencia se encuentra en la literatura la expresión signos radiológicos clásicos (Dyer) (15), referida a la semiología de la radiología convencional.
Derivada de la definición de signo radiológico propuesta previamente puede hacerse una nueva clasificación, siendo el criterio puramente semiológico, es decir, del significado del signo. De esta forma se clasifican los signos en tres grupos:
- Signos indicadores de patología. Son los más abundantes. Pueden sugerir un diagnóstico específico o un listado breve de diagnóstico diferencial. Pertenecen a este grupo, por mencionar alguno, el signo del sombrero de Napoleón invertido (en la espondilolisis con espondilolistesis), el signo del camalote (en el quiste hidatídico roto), el signo de la omega (en la enfermedad de Crohn) o el signo de la cabeza de medusa (en el angioma cerebral).
- Signos indicadores de localización. Corresponden a imágenes que específicamente señalan la localización de una determinada lesión. Es el caso del signo de la silueta, del signo cérvico-torácico, del signo toraco-abdominal o del signo de la embarazada.
- Signos indicadores de normalidad. Se trata de imágenes que determinan la normalidad de un hallazgo. Tienen valor para descartar patología. A este grupo pertenecen, por ejemplo, el signo de la sombra del pezón, el signo del monóculo o el signo de la vela tímica, entre otros.
La metáfora en el aprendizaje de la Radiología
El lenguaje de la Radiología es rico en descripciones de hallazgos, algunas veces metafóricos, que nos permiten recordar fácilmente las imágenes y su correspondiente diagnóstico. Muchos autores han descrito nuevos signos y los han nombrado en función del parecido de la imagen con algún objeto cotidiano: una escalera, un sombrero, una letra, un grano de café o un balón de rugby. La ventaja de estas denominaciones es que resultan tan gráficas que, cuando se descubren en un estudio de un paciente, fácilmente se reconocen. En un artículo reciente, Baker destaca la importancia del uso de las metáforas en Radiología frente a otras especialidades médicas (16).
Ahora bien, sólo puede reconocerse lo que se previamente se conoce. Resulta, pues, necesario, que en la formación de los radiólogos se incluya el aprendizaje de la semiología para el reconocimiento de imágenes patológicas como se reconoce a un familiar nada más verlo. Este último comentario no es gratuito: está tan arraigada la idea del reconocimiento familiar, especialmente entre los radiólogos estadounidenses que, cuando se identifica un diagnóstico rápidamente a partir de una imagen se le llama “caso de la tía Minnie”. El término “tía Minnie” describe una imagen hallada que es perfectamente obvia y patognomónica de una enfermedad (17). Una de las páginas web de Radiología más visitadas es, precisamente, http://www.auntminnie.com. También es conocido el libro “Aunt Minnie’s Atlas and Imaging-Specific Diagnosis”, de Thomas Lee Pope (18).
Según Jaffe (19), en la enseñanza de la Radiología, el reconocimiento de patrones y el desarrollo de la memoria visual juegan un papel primordial. Conocer los signos permite identificar fácilmente algunas patologías o enfocar un diagnóstico, lo que confiere al signo radiológico un indudable valor formativo y justifica plenamente la sección sobre signos que incluye esta nueva revista, de manifiesta orientación educativa.
Bibliografía
- Diccionario de la lengua española. Consulta on line en la página de la Real Academia Española. http://www.rae.es. Visitado el 29 de enero de 2015.
- Collins, J. CT signs and patterns of lung disease. Radiologic Clinics of North America 2001; 39 (6): 1115-1135.
- Eisenberg RL. Atlas de signos radiológicos. Ed. Medici, S.A. Barcelona (España), 1986.
- Curtis P. Langlotz. Comunicación personal.
- Navarro E. Álbum de signos radiológicos. Aplicación multimedia con fines docentes sobre semiología radiológica. Tesis doctoral. Universidad de Málaga (España), 2005. Disponible on line:
http://www-rayos.medicina.uma.es/Rmf/Tesis/Tesis_Doctoral_Eugenio_Navarro.pdf. Visitado el 29 de enero de 2015.
- Aquino SL, Gamsu G, Webb WR, Kee ST. Tree-in-bud pattern: frequency and significance on thin section CT. J Comput Assist Tomogr. 1996; 20(4): 594-599.
- Eisenhuber E. The tree-in-bud sign. Radiology 2002; 222: 771-772.
- Pedrosa CS. Diagnóstico por imagen. Interamericana-McGraw Hill. Madrid, 1986.
- Band KRM. The many ways of saying “pattern” in French medical texts. 22 Meta, XLVI, 1, 2001. Disponible on line:
http://www.erudit.org/revue/meta/2001/v46/n1/001965ar.pdf. Visitado el 29 de enero de 2015.
- http://www.radswiki.net/main/index.php?title=Category:Signs_in_radiology. Visitado el 21 de marzo de 2012.
- Diccionario de signos radiológicos. En: Navarro Sanchis E L, Sendra Portero F. ÁLBUM DE SIGNOS RADIOLÓGICOS v.2.1. CD editado por el Servicio de Publicaciones e Intercambio Científico de la Universidad de Málaga (España) en 2006. ISBN: 84-9747-135-0.
- Rosas H, Cabanillas A. Signos en radiología músculo-esquelética. Rx, US, TAC, RMN. Editorial Roma. Cliclayo (Perú) 2008.
- Rosas H. Comunicación personal.
- Swan CA, Kopans JB, Koerner FC, McArthy KA, White G, Hall DA. The halo sign and malignant breast lesions. AJR Am J Roentgenol 1987; 149: 1145-1147.
- Dyer RB, Chen MY, Zagoria RJ. Classic signs in Uroradiology. Radiographics 2004; 24: S247-S280.
- Baker SR, Partyka L. Relative importance of metaphor in radiology versus other medical specialities. Radiographics 2012; 32: 235-240.
- Applegate KE, Neuhauser DV. Whose Aunt Minnie? Radiology 1999; 211: 292.
- Pope TL. “Aunt Minnie’s Atlas and Imaging-Specific Diagnosis”. Lippincott Williams and Wilkins. Baltimore, 2003.
- Jaffe CC, Lynch PJ. Computer-aided instruction for radiologic education. Radiographics 1993; 13: 931-937.